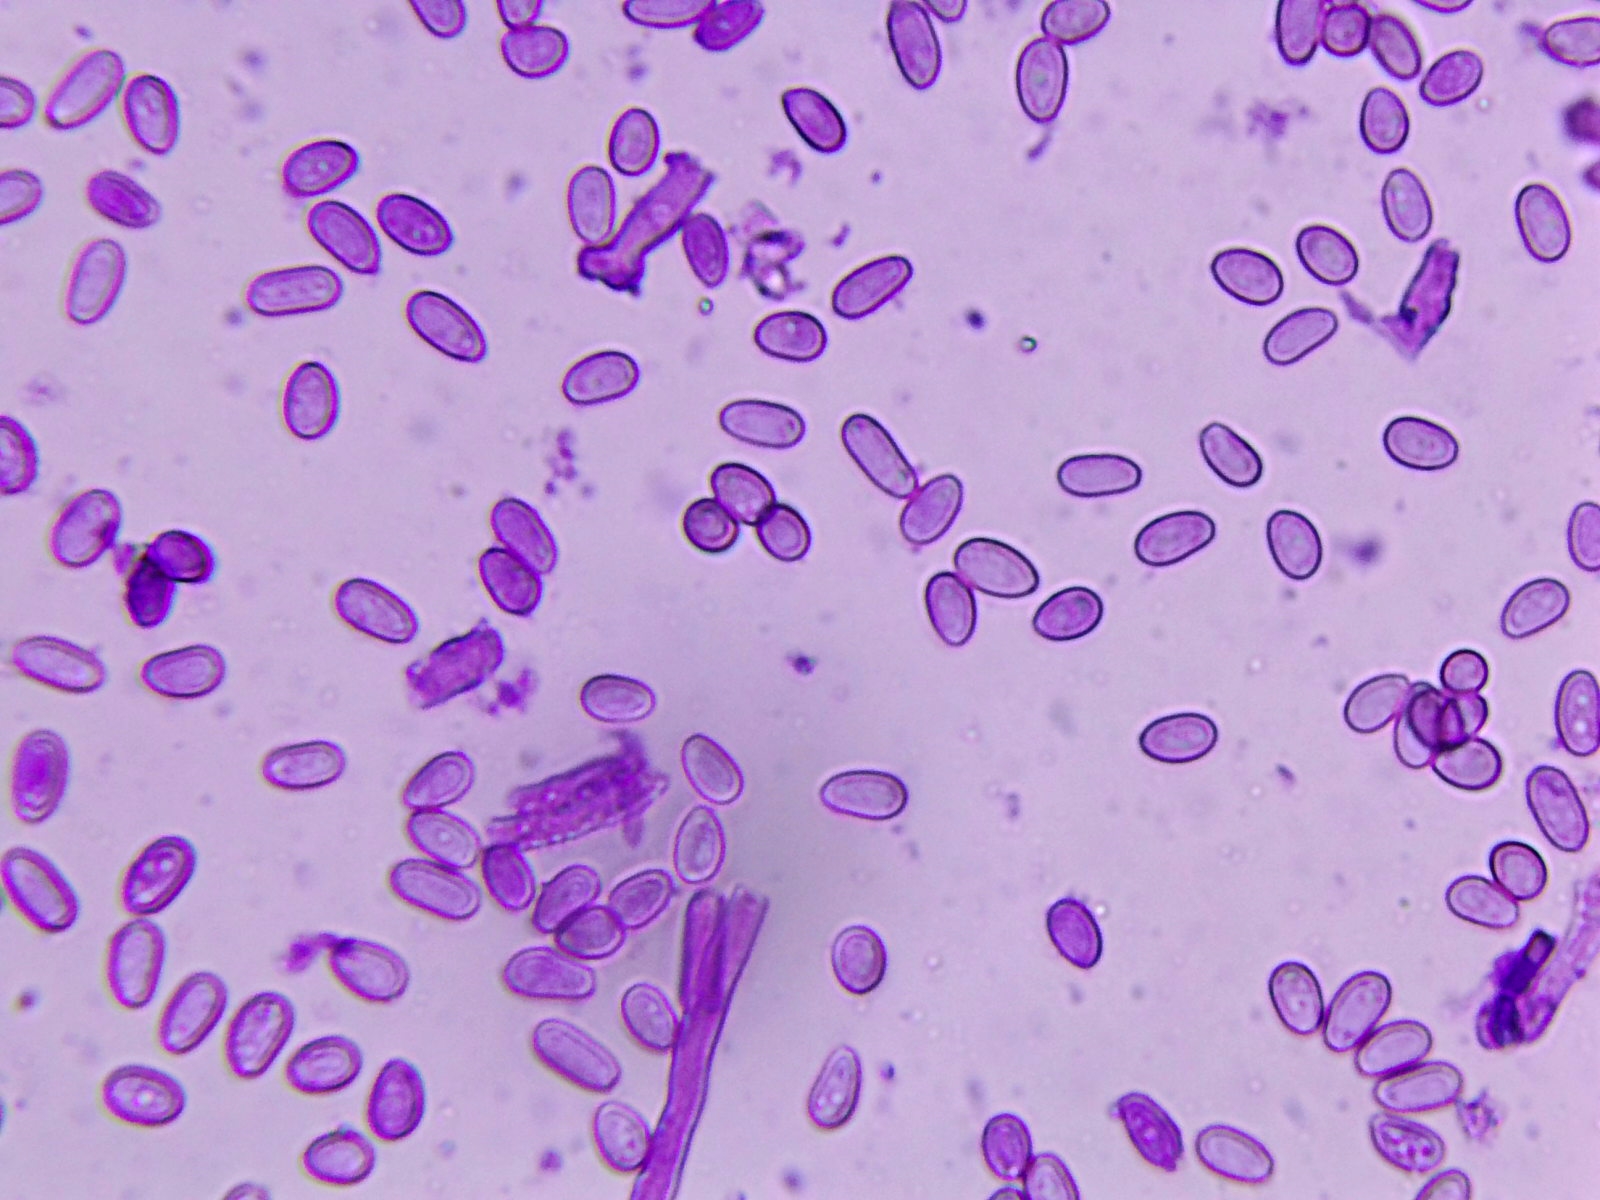

Calcarisporium arbuscula (The luxe)
Calcarisporium arbuscula (The luxe)
- javier
-
 Autor del tema
Autor del tema
- Fuera de línea
- Moderador
-

Menos
Más
- Mensajes: 5617
- Gracias recibidas: 4356
4 años 5 meses antes #106532
por javier
Calcarisporium arbuscula (The luxe) Publicado por javier
Hola forer@s, aunque por esta zona la cosa no esta nada bien micológicamente, al menos he tenido la oportunidad de volver a encontrarme con esta poco conocida especie.Al parecer suelen desarrollarse sobre restos de Hypoxylaceaes tales como por ejemplo: Daldinia concentrica como sospecho que ha sido en mi caso (ver parte inferior de foto donde se encuentra la Daldinia concentrica)Se encontraban en grupos de muchos individuos y en mucha cantidad. Fructificaban sobre troncos o grandes ramas caidas de Chopos. Margenes del Río Guadalquivir (Sevilla)Calcarisporium arbuscula
Ahora la microscopía con Violeta de genciana.
Por último, Daldinia concentrica y en la parte inferior de la imágen un buen grupo de Calcarisporium arbuscula
Deseo que os guste, salu2
Ahora la microscopía con Violeta de genciana.
Por último, Daldinia concentrica y en la parte inferior de la imágen un buen grupo de Calcarisporium arbuscula
Deseo que os guste, salu2
Adjuntos:
Por favor, Identificarse para unirse a la conversación.
- Josep Torres
-

- Fuera de línea
- Moderador
-

Menos
Más
- Mensajes: 8746
- Gracias recibidas: 8379
4 años 5 meses antes #106533
por Josep Torres
Respuesta de Josep Torres sobre el tema Calcarisporium arbuscula (The luxe)
El siguiente usuario dijo gracias: Juan Andrés Román, javier
Por favor, Identificarse para unirse a la conversación.
- Juan Andrés Román
-

- Fuera de línea
- Spammer
-

Menos
Más
- Mensajes: 2558
- Gracias recibidas: 2756
4 años 5 meses antes #106550
por Juan Andrés Román
Respuesta de Juan Andrés Román sobre el tema Calcarisporium arbuscula (The luxe)
El siguiente usuario dijo gracias: javier
Por favor, Identificarse para unirse a la conversación.
- javier
-
 Autor del tema
Autor del tema
- Fuera de línea
- Moderador
-

Menos
Más
- Mensajes: 5617
- Gracias recibidas: 4356
4 años 4 meses antes #106641
por javier
Respuesta de javier sobre el tema Calcarisporium arbuscula (The luxe)
Gracias a todos por las respuestas, la verdad es que estos últomos años por mi zona esta muy pero muy castigada por la sequía, y en estos últomos días parece que están llegando algunas "borrasquitas" aunque tb han bajado mucho las temperaturas, en fin....no paro de llorar
Un abrazo y me alegra que os guste
Un abrazo y me alegra que os guste
El siguiente usuario dijo gracias: Juan Andrés Román, Josep Torres
Por favor, Identificarse para unirse a la conversación.
Tiempo de carga de la página: 0.164 segundos

Foro de micología